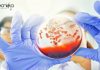
Amity Institute of Microbial Technology Life Sciences JRF Job Amity Institute of Microbial

JRF Vacancies at NIFTEM | MSc Food Science Candidates Apply Now
JRF Vacancies at NIFTEM | MSc Food Science Candidates Apply Now
Are you looking for Food Science Jobs and an exciting research opportunity in the...
Microbiology Job at Amneal Pharmaceuticals | MSc Graduates Apply Now for the Executive Role
Microbiology Job at Amneal Pharmaceuticals | MSc Graduates Apply Now for the Executive Role
If you hold an M.Sc. in Microbiology and are passionate about...
Life Science Job at JNU | Apply Now for Senior Research Fellow Position
Life Science Job at JNU | Apply Now for Senior Research Fellow Position
The School of Life Sciences, Jawaharlal Nehru University (JNU), New Delhi, invites...
BSc Clinical & Life Sciences Clinical Data Associate Job at Novotech, Apply Online
Clinical Data Associate Jobs at Novotech, Life Sciences Apply Online
Clinical Data Associate
Job Description
About the role:
Supports the day-to-day operations of the data management projects, providing...
BRIC-CDFD Research Scholars Program 2026 (PhD-I-2026) Admissions Open
BRIC-CDFD Research Scholars Program 2026 Admissions, CDFD PhD-I-2026
(BRIC-CDFD) CENTRE FOR DNA FINGERPRINTING AND DIAGNOSTICS(A Research Institute under Biotechnology Research and Innovation Council, Department of...
Biotecnika Times Newsletter 01.10.2025 – Govt HPCL, CCMB, PGIMER, BRIC-CDFD Dissertation Program, Wintern Internship...
BioTecNika Info Labs Pvt Ltd | Established 2006 | For you
BioTecNika Times
ONLINE | BANGALORE
18 Years of Service dedicated to Bio Professionals & Biotech Industry
///////////////////////////////////////////////////////////////////////////////////////////////////////////////////////
All India Toll Free Ph:...
Biocon Downstream Processing Job Openings For Life Sciences – Apply Exclusively on Biotecnika
Biocon Downstream Processing Job Openings For Life Sciences - Apply Exclusively on Biotecnika
Name of the Post: Principal Scientist (Downstream Processing)
Location: Bengaluru
Job description
Technical/functional skills:
• Experience...
Biocon Hiring For Mol Bio Role – MSc, MTech Life Sciences Eligible to Apply...
MSc Molecular Biology Jobs at Biocon, Apply On Biotecnika
Name of the Post: Principal Scientist (Molecular Biology)
Location: Bengaluru
Job description
1. Molecular Biology activities involved in making...
How to Crack CSIR NET & GATE with Biotech-Focused Revision Strategies
Smart Strategies to Crack CSIR NET & GATE Exams Efficiently
Preparing for the CSIR NET & GATE exams in Biotechnology can feel like running a...
Life Science Formulation Scientist Job at Puniska Injectables Pvt. Ltd, Apply on Biotecnika
Life Science Formulation Scientist Job at Puniska Injectables Pvt. Ltd, Apply on Biotecnika
Job Title: Formulation Scientist (Full-time, On-site)
Company Name: Puniska Injectables Pvt. Ltd
Experience: 2+...
Biotechnology Project SRF Opportunity – Walk-in Interview at RCB
Biotechnology Project SRF Opportunity - Walk-in Interview at RCB
Advt. No. 47/Project/2025/HR
The Regional Centre for Biotechnology (RCB), Faridabad, invites applications for a Biotechnology Project SRF...
Dissertation-based Research Programme at BRIC-CDFD 2025–26 – Life Sciences Candidates, Apply Now
Research Programme at BRIC-CDFD 2025–26 - Life Sciences Candidates, Apply Now
The Centre for DNA Fingerprinting and Diagnostics (BRIC-CDFD), Hyderabad, invites applications for its Dissertation-Based...
MSc Microbiology Job at St John’s | Apply Now for Project Technician Support Role
MSc Microbiology Job at St John's | Apply Now for Project Technician Support Role
Are you looking for a Microbiological Job or a rewarding career...
Cargill Careers for Food Science Graduates | Apply Now for FSQR- Officer Role
Cargill Careers for Food Science Graduates | Apply Now for FSQR- Officer Role
Are you looking for a Food Science Job in an exciting career...
Biology Jobs at IISER Thiruvananthapuram – Apply Now For Project Associate Role
Biology Jobs at IISER Thiruvananthapuram - Apply Now For Project Associate Role
Indian Institute of Science Education and Research Thiruvananthapuram (IISER-TVM) invites applications for Biology...